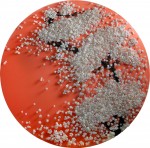
Инсталляция | Ran Hwang | 04

Казалось бы, очевидно, что человек в здравом рассудке никогда не будет приобретать в огромном количестве всевозможные булавки и пуговицы, если он, к примеру, не планирует заготавливать их на зиму посредством закатывания в банки. Такое поведение нам может показаться странным, но только не в том случае, если этот человек дизайнер или художник.
Именно такие закупки и совершает корейская художница из Сеула — Рэн Вонг (Ran Hwang), когда собирается воспроизвести свою очередную ошеломительную задумку.
Для воплощения каждой из таких идей художнице требуется чрезвычайное упорство и терпение, а также умопомрачительное число одноцветных пуговиц, одинаковых по величине и форме, и столько же разнообразных булавок. В своей работе Рэн Вонг никогда не использует такие подручные средства, как проволока, клей, скотч — только булавки, которые как раз удерживают пуговицы в нужном положении и на необходимом расстоянии одна от другой. Примечательно, что её работу можно оценить по достоинству лишь с большого расстояния, так как вблизи картина выглядит очень размыто, нечётко. Но именно это и придает особую изюминку ее творениям.
Эта гениальная корейская художница уверяет: «За время работы над своими шедеврами я стала еще более спокойной и намного терпеливее». Также Рэн Вонг неоднократно утверждала, что воспринимает сам процесс создания своих произведений как своеобразную духовную практику. Еще будучи подростком, эта девушка окончила одну из довольно известных нью-йоркских школ для начинающих художников - School of Visual Arts.
Работы Рэн – это удивительное сочетание классической живописи и современной скульптуры. Для каждой картины художница подбирает особый индивидуальный фон, что влияет на восприятие ее задумки зрителем. К примеру, ярко-белая, цвета снега, сакура на белоснежном фоне – песня души, посвящена полнолунию, на фоне красного – закату белой окраски, а на бледно-синем фоне – второй внезапной любви.
Рэн Вонг приходится немало времени проводить около стены-полотна, нанизывая большое количество маленьких пуговок на булавки и планомерно вкалывая их в определенные места! О прекрасном результате ее творчества говорит то, что фестивали и выставки этой художницы посещает значительное количество людей. Они восхищаются этими удивительными панно, вдохновляя ее на создание новых, восхитительных и неповторимых, работ. А эти выставки и фестивали проходят в крупных городах, в список которых входят Гонконг, Париж и, конечно же, Сеул, родной город художницы.
Свои лучшие творения ставшая известной на весь мир Рэн Вонг собирается представить и на выставке, проходящей в городе Hampton, штат Верджиния, США, в летний период 2014-го года. Их смогут увидеть не только специалисты, но и все желающие.